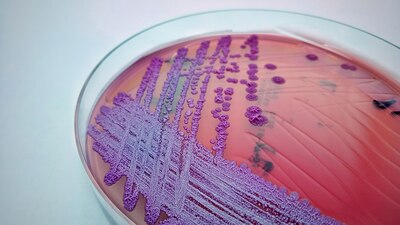
Es una enfermedad endémica de lugares con clima tropical como el sudeste de Asia y el norte de Australia

Estados Unidos reportó dos acontecimientos relevantes en materia de salud esta semana. Apenas dos días después de registrar el primer caso de poliomielitis en casi una década, los Centros para el Control y la Prevención de Enfermedades (CDC, por sus siglas en inglés) identificaron la bacteria que causa la rara y grave enfermedad llamada melioidosis dentro del país.
La bacteria Burkholderia pseudomallei o B. pseudomallei se identificó en muestras de suelo y agua en la región de la costa del Golfo de Mississippi. Esto después de que dos personas no relacionadas que vivían muy cerca de la zona enfermaran de melioidosis, una en 2020 y la otra en 2022.
A raíz de esto fue que los funcionarios de salud estatales y los CDC tomaron muestras de los productos domésticos, el suelo y el agua de la región para analizarlos. Se identificó la bacteria en tres de las muestras de agua y suelo, lo que indica que ha estado presente en el área al menos desde 2020.
Hasta el momento se desconoce en qué otros lugares del territorio podría encontrarse, sin embargo, los centros sugieren que las condiciones ambientales de la costa del Golfo son propicias para su crecimiento.
Tras del hallazgo, los CDC alertaron a todos los médicos del país y les pidieron estar al tanto de los signos y síntomas de la enfermedad en sus pacientes.
La bacteria causa melioidosis y puede ser grave en personas que tengan enfermedades subyacentes. https://t.co/MMIN1Pmp1E
— BBC News Mundo (@bbcmundo) July 28, 2022
En Estados Unidos se registra un promedio de 12 casos al año en personas que viajaron a un país donde la bacteria es endémica. Los casos también han sido relacionados con productos comerciales contaminados importados de dichos países.
Dada la mínima cantidad de contagios, los CDC consideran que el riesgo de melioidosis para la población general sigue siendo muy bajo.
¿Qué es la melioidosis?
La melioidosis, también llamada enfermedad de Whitmore, es una enfermedad infecciosa causada por la bacteria Burkholderia pseudomallei o B. pseudomallei, que se encuentra en suelos y aguas contaminadas, de acuerdo con información de los CDC.
La enfermedad puede transmitirse a humanos y animales a través del contacto directo con la fuente contaminada.
Se encuentra predominantemente en lugares con climas tropicales, especialmente en el sudeste de Asia y el norte de Australia, donde está muy extendida
¿Cuáles son los síntomas de la melioidosis?
La melioidosis tiene una amplia gama de síntomas inespecíficos que pueden confundirse con los de otras enfermedades como la tuberculosis o formas comunes de neumonía.
Las personas infectadas pueden presentar fiebre, dolor en las articulaciones y dolores de cabeza, además de afecciones que incluyen neumonía, formación de abscesos o infecciones de la sangre.
A nivel mundial, la melioidosis es mortal en 10 a 50 por ciento de las personas infectadas.